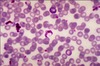

Oral cavity:
Describe the following for Cleft lip & palate:
What is it?
What causes it?
Patho:
When the facial prominences fail to fuse during early pregnancy (they usually appear together)
Causes:
Teratogenic drugs

Patho:
When the facial prominences fail to fuse during early pregnancy (they usually appear together)
Causes:
Teratogenic drugs
Describes which condition?

Cleft Lip & palate
Describe the following for aphthous ulcers:
What are they?
What causes them?
Patho:
Aka cancer sores that look gray/blue with surrounding erythema. They are painful & superficial sores in the mouth
Causes:
Stress/illness
Bechet syndrome

Patho:
Aka cancer sores that look gray/blue with surrounding erythema. They are painful & superficial sores in the mouth
Causes:
Stress/illness
Bechet syndrome
Describes which type of ulcer?

Aphthous ulcer
Describe the following for Oral herpes:
What is it?
What causes it?
What is a complication of a primary infection?
Patho:
An infection causes the mucosal vesicles to rupture resulting in shallow & painful red ulcers (cold sores)
Causes:
HSV-1 infection
Comp:
If you contract a primary HSV-1 infection in childhood the lesions will heal but the virus will lie dormant in the trigeminal ganglia & can reactivate in response to stress & sunlight (life long)

Patho:
An infection causes the mucosal vesicles to rupture resulting in shallow & painful red ulcers (cold sores)
Causes:
HSV-1 infection
Comp:
If you contract a primary HSV-1 infection in childhood the lesions will heal but the virus will lie dormant in the trigeminal ganglia & can reactivate in response to stress & sunlight (life long)
Describes which condition?

Oral herpes (HSV-1)
Describe the following for Bechet syndrome:
What is it?
What causes it?
Patho:
Immune complex vasculitis affecting smaller blood vessels causes recurrent uveitis, aphthous & genital ulcers.
Causes:
Typically post viral infection
Patho:
Immune complex vasculitis affecting smaller blood vessels causes recurrent uveitis, aphthous & genital ulcers.
Causes:
Typically post viral infection
Describes which condition?
Bechet syndrome
Describe the following for Squamous cell cancer (mouth):
What is it?
What causes it?
- risks
What are the lab findings?
- histology
What are the differentials?
Patho:
A malignant neoplasm of squamous cells lining the mouth. It presents with precursor lesions i.e leukoplakia & erythroplakia
Causes/risks:
- Smoking
- Drinking
- Genetics
Lab/histo:
Leukoplakia (A white plaque that can’t be scraped off)
Erythroplasia (A red plaque aka vascularized squamous cell dysplasia)
Both represent squamous cell dysplasia
Differentials:
- Oral Candidiasis (white plaque that’s easily scraped off usually in immunocompromised )
- Hairy leukoplakia (lateral side tongue plaque seen in immunocompromised plp with EBV infection)

Patho:
A malignant neoplasm of squamous cells lining the mouth. It presents with precursor lesions i.e leukoplakia & erythroplakia
Causes/risks:
- Smoking
- Drinking
- Genetics
Lab/histo:
Leukoplakia (A white plaque that can’t be scraped off)
Erythroplasia (A red plaque aka vascularized squamous cell dysplasia)
Both represent squamous cell dysplasia
Differentials:
- Oral Candidiasis (white plaque that’s easily scraped off usually in immunocompromised )
- Hairy leukoplakia (lateral side tongue plaque seen in immunocompromised plp with EBV infection)
Describes which condition?

Squamous cell cancer (mouth)
Describe the following for Mumps:
What is it?
What causes it?
What are the symptoms?
What are the lab findings?
What is a possible complication?
Patho:
Infection causing bilateral parotid inflammation & swelling
Causes:
Mump virus
Signs:
1) Orchitis (inflamed testes)
2) Pancreatitis
3) Aseptic meningitis
Labs:
Elevated serum amylase
Comp:
Sterility in teenagers

Patho:
Infection causing bilateral parotid inflammation & swelling
Causes:
Viral infection
Signs:
1) Orchitis (inflamed testes)
2) Pancreatitis
3) Aseptic meningitis
Labs:
Elevated serum amylase
Comp:
Sterility in teenagers
Describes which condition?

Mumps
Describe the following for a pleomorphic adenoma:
What is it?
What are the symptoms?
What are the lab findings?
- histology
What is a rare complication?
Patho:
A benign tumor in the salivary glands (#1 Parotid). It is a mobile, painless, & circumscribed mass at the angle of the jaw it has a high rate of reoccurrence
Signs:
1) Facial nerve damage
Labs/histo:
Tumor is made from Stromal (cartilage) & epithelial tissue
&
There is extension of tumor islands outside the tumor capsule (incomplete resection)
Comp:
It rarely progresses to a carcinoma

Patho:
A benign tumor in the salivary glands (#1 Parotid). It is a mobile, painless, & circumscribed mass at the angle of the jaw it has a high rate of reoccurrence
Signs:
1) Facial nerve damage
Labs/histo:
Tumor is made from Stromal (cartilage) & epithelial tissue
&
There is extension of tumor islands outside the tumor capsule (incomplete resection)
Comp:
It rarely progresses to a carcinoma
Describes which condition?

Pleomorphic adenoma
A patient presents to the clinic with facial palsy & a painless mobile mass at the jaw angle.
What is a possible diagnosis?
What is the concern with surgery?
What is a possible complication?

Diagnosis:
Pleomorphic adenoma
Surgery concern:
The tumor has many small island extensions outside of the original tumor capsule making it difficult to resect completely (high recurrence rate)
Comp:
In rare cases it can transform into a carcinoma (malignant tumor)
Which is the most common benign tumor of the salivary gland?
Pleomorphic adenoma (parotid)

Which is the 2nd most common benign tumor of the salivary gland?
Warthin tumor (parotid)

What is the most common malignant tumor of the salivary gland?
Mucoepidermoid carcinoma (parotid)
Describe the following for a Warthin tumor:
What is it & what are the lab findings (histo)?
Patho/histo:
A benign cystic tumor with lots of lymphocytes & germinal centers (lymph node-like stroma)
It’s the second most common benign tumor of the salivary (parotid) gland

Patho/histo:
A benign cystic tumor with lots of lymphocytes & germinal centers (lymph node-like stroma)
It’s the second most common benign tumor of the salivary (parotid) gland
Describes which condition?

Warthin tumor
Describe the following for a mucoepidermoid carcinoma:
What is it & what are the lab findings (histo)?
Patho/labs (histo):
A malignant tumor made of mucinous & squamous cells
It is the most common malignant tumor of the salivary gland (parotid)

Patho/labs (histo):
A malignant tumor made of mucinous & squamous cells
It is the most common malignant tumor of the salivary gland (parotid)
Describes which condition?

Mucoepidermoid carcinoma
Describe the following for a transesophageal fistula:
What is it?
- most common variant
What are the symptom?
Patho:
A congenital defect resulting in a connection between the esophagus & trachea
most common var:
A proximal esophageal atresia with & the distal esophagus connecting to the trachea
Signs:
1) Vomiting
2) Polyhydramnios
3) Abdominal distension & aspiration (air)

Patho:
A congenital defect resulting in a connection between the esophagus & trachea
most common var:
A proximal esophageal atresia with & the distal esophagus connecting to the trachea
Signs:
1) Vomiting
2) Polyhydramnios
3) Abdominal distension & aspiration (air)
Describes which condition?

Tracheoesophageal fistula